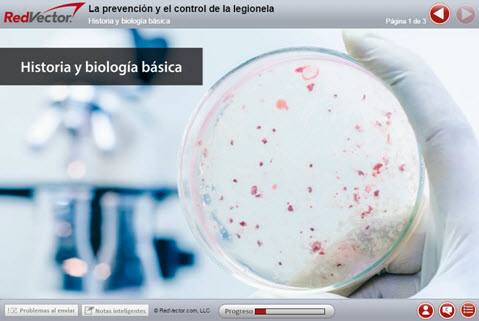

Legionella Prevention and Control (La prevención y el control de la legionela)
0.5 hrs. Online Course
Level: Intermediate
Average Rating: (29)
Item #: RVISP-11016
SME: Neil Smith CIH CSP CHMM
Level: Intermediate
Average Rating: (29)
Item #: RVISP-11016
SME: Neil Smith CIH CSP CHMM
NOTE: State license renewal information is provided as a convenience only and is subject to change at any time. It is the ultimate responsibility of the individual to be sure that he or she is meeting continuing education requirements for each license and corresponding renewal period. Information above was pulled on Friday, June 26, 2026.












